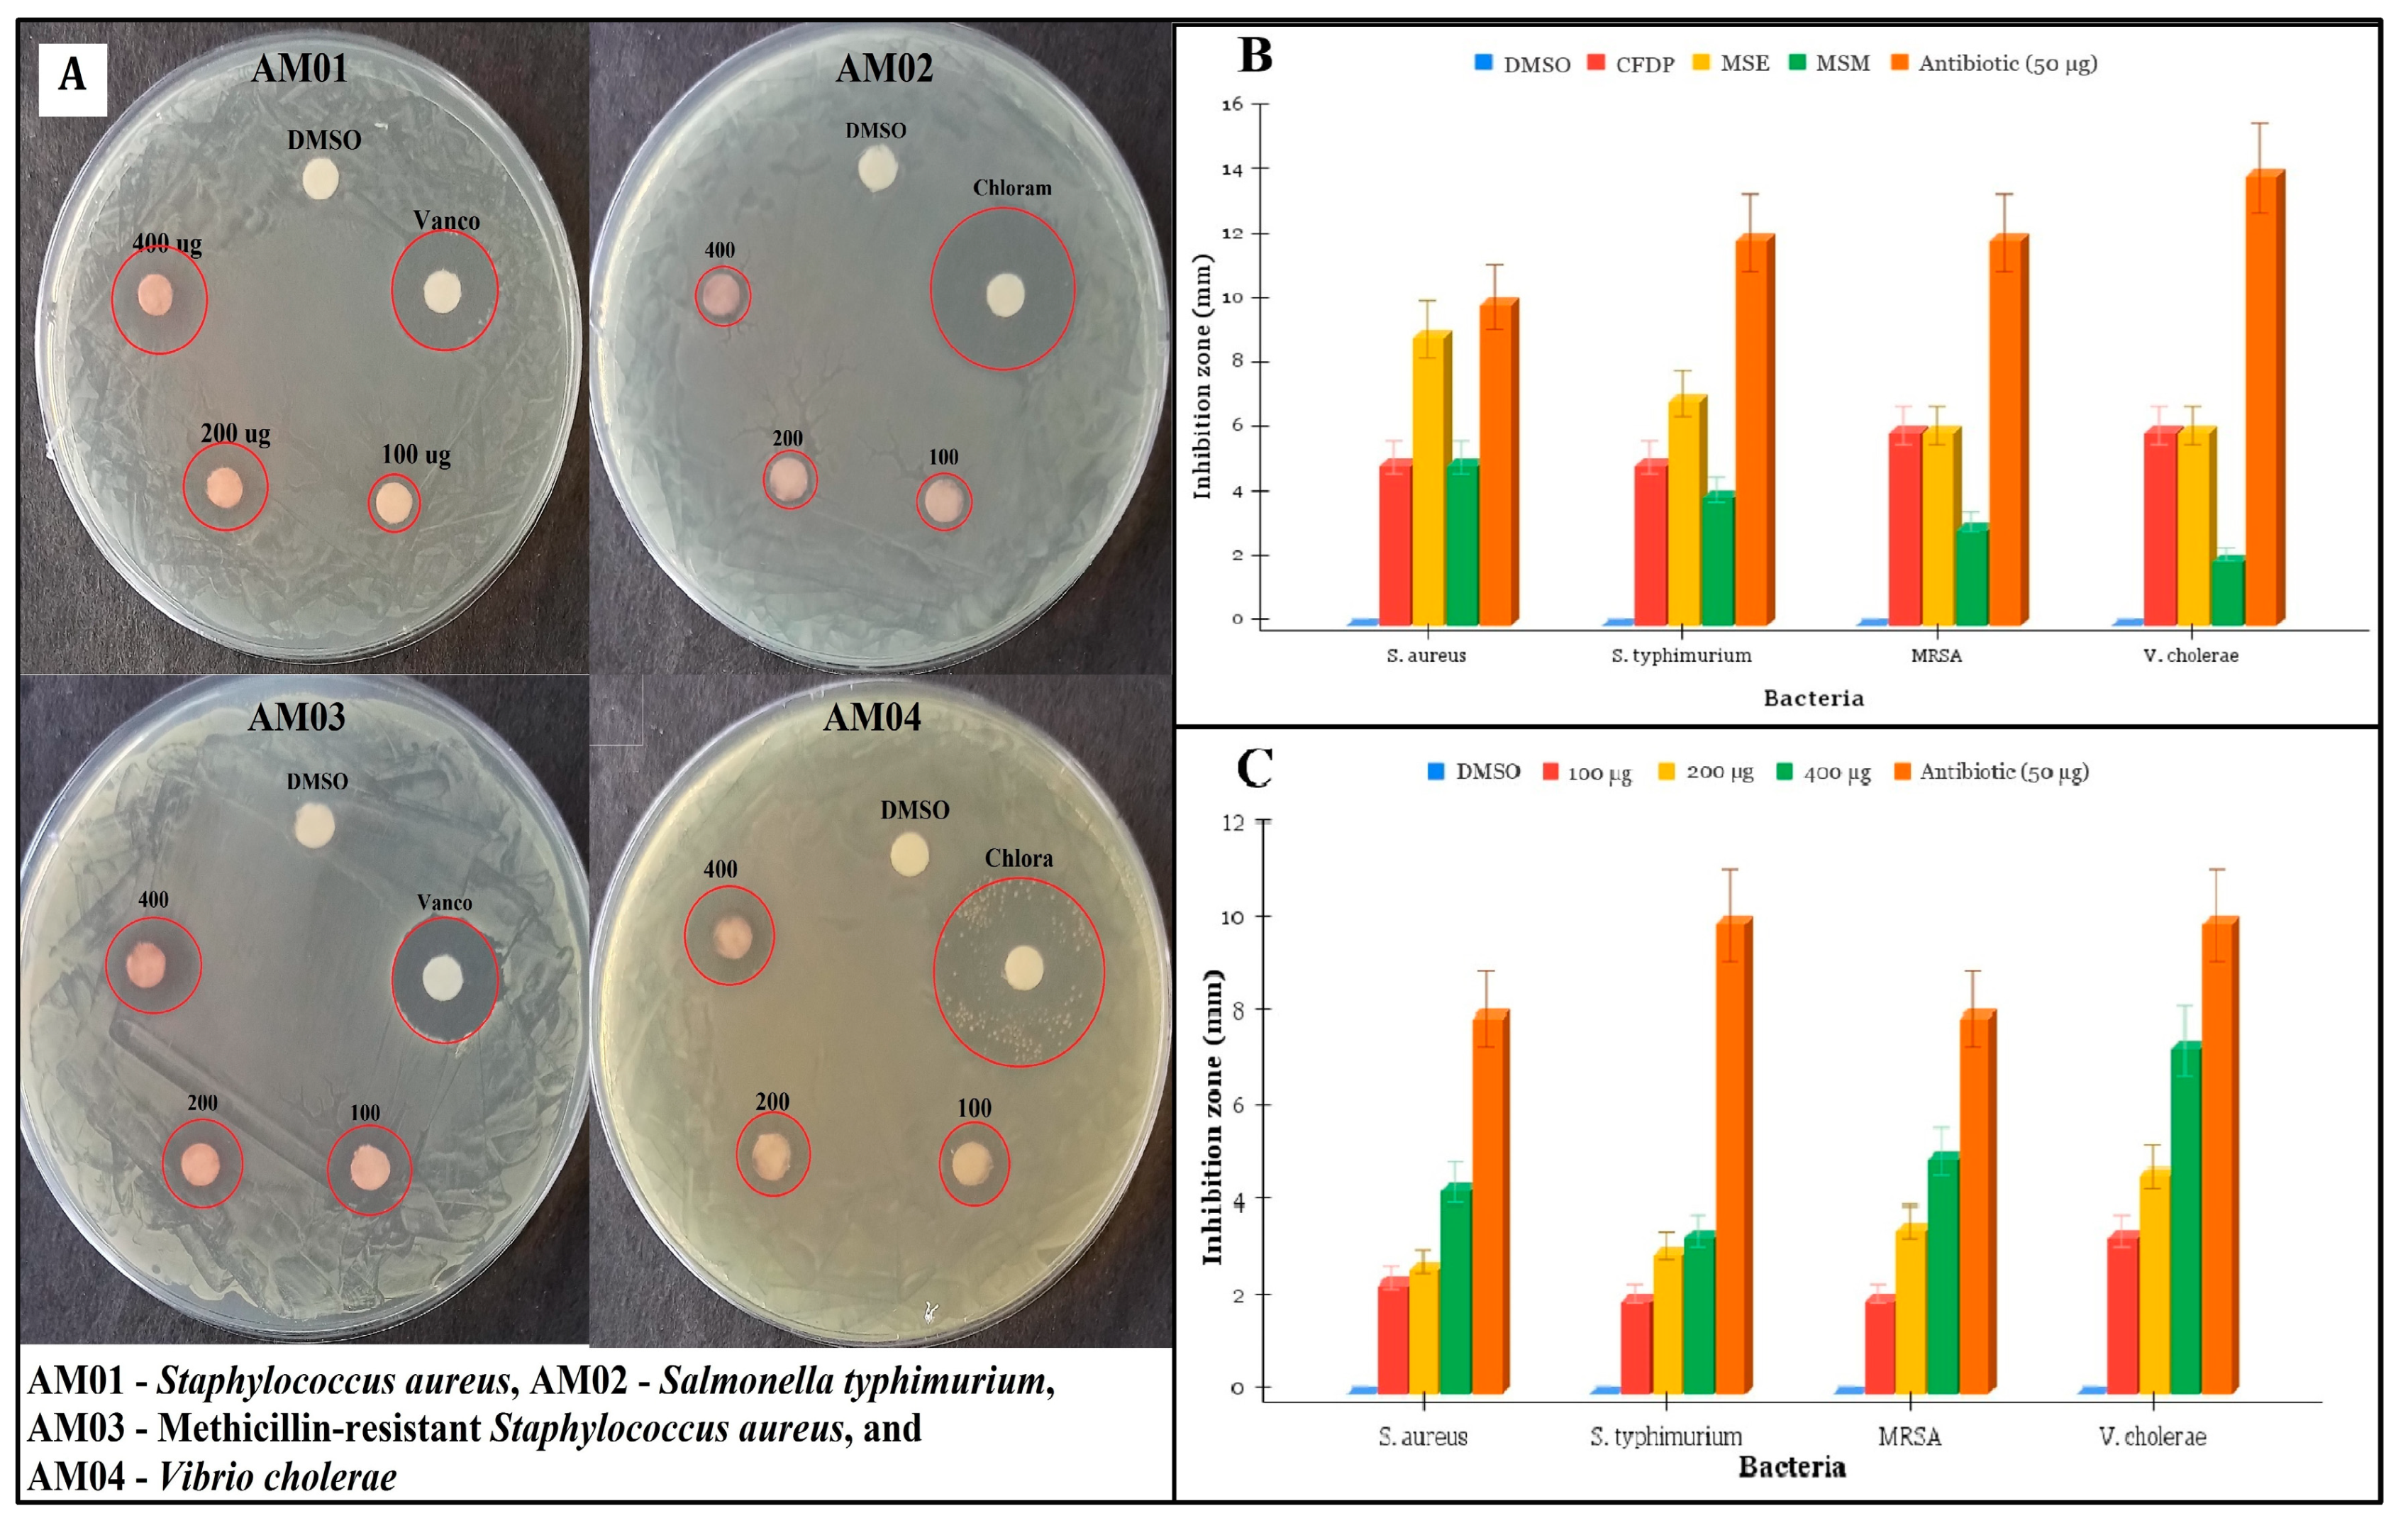
Fermentation 09 00328 g003

Characterization of the Red Biochromes Produced by the Endophytic Fungus Monascus purpureus CPEF02 with Antimicrobial and Antioxidant Activities
Abstract
1. Introduction
2. Materials and Methods
2.1. Isolation, Cultivation and Identification of Pigment-Producing Endophytic Fungi
2.2. Screening of Culture Media for Pigment Production and Extraction Optimization of CPEF02
2.3. Quantification of Extracellular Polyketide Red Pigment
2.4. Antimicrobial Assays
2.4.1. Antibacterial Assay
2.4.2. Antifungal Assays
2.5. Antioxidant Assay
2.6. LC-HRMS Analysis
3. Results
3.1. Identification and Characterization of Pigment-Producing Endophytic Fungus
3.2. Screening of Culture Media for Pigment Production and Solvent Extraction by CPEF02
3.3. Antimicrobial Activity of CPEF02 Extracts
3.4. Antioxidant Activity of CPEF02 Colourant
3.5. LC-HRMS Profiling of CPEF02 Pigments
4. Conclusions
Author Contributions
Funding
Institutional Review Board Statement
Informed Consent Statement
Data Availability Statement
Conflicts of Interest
References
- Fried, R.; Oprea, I.; Fleck, K.; Rudroff, F. Biogenic Colourants in the Textile Industry—A Promising and Sustainable Alternative to Synthetic Dyes. Green Chem. 2022, 24, 13–35. [Google Scholar] [CrossRef]
- Bai, Y.; Kissoudis, C.; Yan, Z.; Visser, R.G.F.; van der Linden, G. Plant Behaviour under Combined Stress: Tomato Responses to Combined Salinity and Pathogen Stress. Plant J. 2018, 93, 781–793. [Google Scholar] [CrossRef]
- Kalra, R.; Conlan, X.A.; Goel, M. Fungi as a Potential Source of Pigments: Harnessing Filamentous Fungi. Front. Chem. 2020, 8, 369. [Google Scholar] [CrossRef]
- Zheng, Y.; Xin, Y.; Guo, Y. Study on the Fingerprint Profile of Monascus Products with HPLC–FD, PAD and MS. Food Chem. 2009, 113, 705–711. [Google Scholar] [CrossRef]
- Chen, W.; Chen, R.; Liu, Q.; He, Y.; He, K.; Ding, X.; Kang, L.; Guo, X.; Xie, N.; Zhou, Y.; et al. Orange, Red, Yellow: Biosynthesis of Azaphilone Pigments in Monascus Fungi. Chem. Sci. 2017, 8, 4917–4925. [Google Scholar] [CrossRef]
- He, J.; Jia, M.; Li, W.; Deng, J.; Ren, J.; Luo, F.; Bai, J.; Liu, J. Toward Improvements for Enhancement the Productivity and Color Value of Monascus Pigments: A Critical Review with Recent Updates. Crit. Rev. Food Sci. Nutr. 2021, 62, 7139–7153. [Google Scholar] [CrossRef]
- Lagashetti, A.C.; Dufossé, L.; Singh, S.K.; Singh, P.N. Fungal Pigments and Their Prospects in Different Industries. Microorganisms 2019, 7, 604. [Google Scholar] [CrossRef]
- Abdollahi, F.; Jahadi, M.; Ghavami, M. Thermal Stability of Natural Pigments Produced by Monascus purpureus in Submerged Fermentation. Food Sci. Nutr. 2021, 9, 4855–4862. [Google Scholar] [CrossRef]
- Turgay, O.; Azirak, S. A Review on the Red Yeast Rice (Monascus purpureus). Turk. Electron. J. Biotechnol. 2004, 2, 37–49. [Google Scholar]
- Mishra, R.C.; Kalra, R.; Dilawari, R.; Deshmukh, S.K.; Barrow, C.J.; Goel, M. Characterization of an Endophytic Strain Talaromyces assiutensis, CPEF04 with Evaluation of Production Medium for Extracellular Red Pigments Having Antimicrobial and Anticancer Properties. Front. Microbiol. 2021, 12, 665702. [Google Scholar] [CrossRef]
- Lebeau, J.; Venkatachalam, M.; Fouillaud, M.; Petit, T.; Vinale, F.; Dufossé, L.; Caro, Y. Production and New Extraction Method of Polyketide Red Pigments Produced by Ascomycetous Fungi from Terrestrial and Marine Habitats. J. Fungi 2017, 3, 34. [Google Scholar] [CrossRef]
- Weinstein, M.P. Clinical and Laboratory Standards Institute. Performance Standards for Antimicrobial Susceptibility Testing; Clinical and Laboratory Standards Institute: Wayne, PA, USA, 2021. [Google Scholar]
- Aguilar-Méndez, M.A.; San Martín-Martínez, E.; Ortega-Arroyo, L.; Cobián-Portillo, G.; Sánchez-Espíndola, E. Synthesis and Characterization of Silver Nanoparticles: Effect on Phytopathogen Colletotrichum gloesporioides. J. Nanoparticle Res. 2010, 13, 2525–2532. [Google Scholar] [CrossRef]
- Almeida, A.B.D.; de Lima, T.M.; Santos, N.H.; Santana, R.V.; dos Santos, S.C.; Egea, M.B. An Alternative for Corn Bran Byproduct: Fermentation Using M. purpureus. Nutr. Food Sci. 2019, 50, 515–527. [Google Scholar] [CrossRef]
- Rasheva, T.; Hallet, J.-N.; Kujumdzieva, A. Taxonomic investigation of Monascus purpureus 94-25 strain. J. Cult. Collect. 1998, 2, 51–59. [Google Scholar]
- Parul; Thiyam, G.; Dufossé, L.; Sharma, A.K. Characterization of Talaromyces purpureogenus Strain F Extrolites and Development of Production Medium for Extracellular Pigments Enriched with Antioxidant Properties. Food Bioprod. Process. 2020, 124, 143–158. [Google Scholar] [CrossRef]
- Mehri, D.; Perendeci, N.A.; Goksungur, Y. Utilization of Whey for Red Pigment Production by Monascus purpureus in Submerged Fermentation. Fermentation 2021, 7, 75. [Google Scholar] [CrossRef]
- De Carvalho, J.C.; Oishi, B.; Woiciechowski, A.L.; Pandey, A.; Sumathy, B.; Socool, C. Effect of Substrates on the Production of Monascus Biopigments by Solid-State Fermentation and Pigment Extraction Using Different Solvents. Indian J. Biotechnol. 2007, 6, 194–199. [Google Scholar]
- Padmavathi, T.; Prabhudessai, T. A Solid Liquid State Culture Method to Stimulate Monascus Pigments by Intervention of Different Substrates. Int. Res. J. Biol. Sci. 2013, 2, 22–29. [Google Scholar]
- Chaudhary, V.; Katyal, P.; Panwar, H.; Puniya, A.K.; Poonia, A.K. Evaluating Anti-Microbial and Anti-Oxidative Potential of Red Biopigment from Monascus purpureus. Environ. Conserv. J. 2022, 23, 83–93. [Google Scholar] [CrossRef]
- de Almeida, A.B.; Santos, N.H.; de Lima, T.M.; Santana, R.V.; de Oliveira Filho, J.G.; Peres, D.S.; Egea, M.B. Pigment Bioproduction by Monascus purpureus Using Corn Bran, a Byproduct of the Corn Industry. Biocatal. Agric. Biotechnol. 2021, 32, 101931. [Google Scholar] [CrossRef]
- Cheng, M.-J.; Wu, M.-D.; Chen, I.-S.; Tseng, M.; Yuan, G.-F. Chemical Constituents from the Fungus Monascus purpureus and Their Antifungal Activity. Phytochem. Lett. 2011, 4, 372–376. [Google Scholar] [CrossRef]
- Gökmen, G.G.; Şılbır, M.S.; Göksungur, Y.; Kışla, D. Antimicrobial Activity of Red Pigments Derived from Monascus purpureus: A Comparison to Industrial Red Pigments. JSFA Rep. 2021, 1, 5–10. [Google Scholar] [CrossRef]
- Yudiarti, T.; Sugiharto, S.; Isroli, I.; Widiastuti, E.; Wahyuni, H.; Sartono, T. Effect of Fermentation Using Chrysonillia crassa and Monascus purpureus on Nutritional Quality, Antioxidant, and Antimicrobial Activities of Used Rice as a Poultry Feed Ingredient. J. Adv. Vet. Anim. Res. 2019, 6, 168. [Google Scholar] [CrossRef] [PubMed]
- Kim, B.; Ryu, J.; Jang, S.O.; Kim, M. Antioxidant Activity and Cell Differentiation Effects of Monascus purpureus Pigment on Osteoblast-like MC3T3-E1 Cells. J. Life Sci. 2020, 30, 468–475. [Google Scholar]
- Dahle, M.A.; Divakar, S.; Kumar, S.U.; Vijayalakshmi, G. Isolation and Characterization of Dihydromonacolin-MV from Monascus purpureus for Antioxidant Properties. Appl. Microb. Cell Physiol. 2007, 73, 1197–1202. [Google Scholar] [CrossRef]
- Yeh, Y.-H.; Hsieh, Y.-L.; Lee, Y.-T. Effect of RYR, MFA and MFB on Serum Lipids and Antioxidant Activity in Rats. e-SPEN J. 2012, 7, e176–e181. [Google Scholar] [CrossRef]
- Hsu, Y.-W.; Hsu, L.-C.; Chang, C.-L.; Liang, Y.-H.; Kuo, Y.-H.; Pan, T.-M. New Anti-Inflammatory and Anti-Proliferative Constituents from Fermented Red Mold Rice Monascus purpureus NTU 568. Molecules 2010, 15, 7815–7824. [Google Scholar] [CrossRef]
- Loret, M.-O.; Morel, S. Isolation and Structural Characterization of Two New Metabolites from Monascus. J. Agric. Food Chem. 2010, 58, 1800–1803. [Google Scholar] [CrossRef]
- Mapari, S.A.S.; Hansen, M.E.; Meyer, A.S.; Thrane, U. Computerized Screening for Novel Producers of Monascus-like Food Pigments in Penicillium Species. J. Agric. Food Chem. 2008, 56, 9981–9989. [Google Scholar] [CrossRef]
- Hsu, Y.-W.; Hsu, L.-C.; Liang, Y.-H.; Kuo, Y.-H.; Pan, T.-M. Monaphilones A−C, Three New Antiproliferative Azaphilone Derivatives from Monascus purpureus NTU 568. J. Agric. Food Chem. 2010, 58, 8211–8216. [Google Scholar] [CrossRef]
- Yuliana, A.; Singgih, M.; Julianti, E.; Blanc, P.J. Derivates of Azaphilone Monascus Pigments. Biocatal. Agric. Biotechnol. 2017, 9, 183–194. [Google Scholar] [CrossRef]
- Lin, C.-P.; Lin, Y.-L.; Huang, P.-H.; Tsai, H.-S.; Chen, Y.-H. Inhibition of Endothelial Adhesion Molecule Expression by Monascus purpureus-Fermented Rice Metabolites, Monacolin K, Ankaflavin, and Monascin. J. Sci. Food Agric. 2011, 91, 1751–1758. [Google Scholar] [CrossRef] [PubMed]
- Shi, Y.-C.; Liao, V.H.-C.; Pan, T.-M. Monascin from Red Mold Dioscorea as a Novel Antidiabetic and Antioxidative Stress Agent in Rats and Caenorhabditis elegans. Free Radic. Biol. Med. 2012, 52, 109–117. [Google Scholar] [CrossRef] [PubMed]
- Hsu, W.-H.; Lee, B.-H.; Liao, T.-H.; Hsu, Y.-W.; Pan, T.-M. Monascus-Fermented Metabolite Monascin Suppresses Inflammation via PPAR-γ Regulation and JNK Inactivation in THP-1 Monocytes. Food Chem. Toxicol. 2012, 50, 1178–1186. [Google Scholar] [CrossRef] [PubMed]
- Hsu, L.-C.; Liang, Y.-H.; Hsu, Y.-W.; Kuo, Y.-H.; Pan, T.-M. Anti-Inflammatory Properties of Yellow and Orange Pigments from Monascus purpureus NTU 568. J. Agric. Food Chem. 2013, 61, 2796–2802. [Google Scholar] [CrossRef]
- Jou, P.-C.; Ho, B.-Y.; Hsu, Y.-W.; Pan, T.-M. The Effect of Monascus Secondary Polyketide Metabolites, Monascin and Ankaflavin, on Adipogenesis and Lipolysis Activity in 3T3-L1. J. Agric. Food Chem. 2010, 58, 12703–12709. [Google Scholar] [CrossRef]
- Lee, C.-L.; Wen, J.-Y.; Hsu, Y.-W.; Pan, T.-M. Monascus-Fermented Yellow Pigments Monascin and Ankaflavin Showed Antiobesity Effect via the Suppression of Differentiation and Lipogenesis in Obese Rats Fed a High-Fat Diet. J. Agric. Food Chem. 2013, 61, 1493–1500. [Google Scholar] [CrossRef]
- Mapari, S.A.; Meyer, A.S.; Thrane, U.; Frisvad, J.C. Identification of Potentially Safe Promising Fungal Cell Factories for the Production of Polyketide Natural Food Colorants Using Chemotaxonomic Rationale. Microb. Cell Factories 2009, 8, 24. [Google Scholar] [CrossRef]
- Kaur, B.; Chakraborty, D.; Kaur, H. Production and Evaluation of Physicochemical Properties of Red Pigment from Monascus purpureus MTCC 410. Internet J. Microbiol. 2009, 7, 1–7. [Google Scholar]
- Li, J.-J.; Shang, X.-Y.; Li, L.-L.; Liu, M.-T.; Zheng, J.-Q.; Jin, Z.-L. New Cytotoxic Azaphilones from Monascus purpureus-Fermented Rice (Red Yeast Rice). Molecules 2010, 15, 1958–1966. [Google Scholar] [CrossRef]
- Mukherjee, G.; Singh, S.K. Purification and Characterization of a New Red Pigment from Monascus purpureus in Submerged Fermentation. Process. Biochem. 2011, 46, 188–192. [Google Scholar] [CrossRef]
- Feng, Y.; Shao, Y.; Chen, F. Monascus Pigments. Appl. Microbiol. Biotechnol. 2012, 96, 1421–1440. [Google Scholar] [CrossRef] [PubMed]
- Sato, K.; Goda, Y.; Sakamoto Sasaki, S.; Shibata, H.; Maitani, T.; Yamada, T. Identification of Major Pigments Containing D-Amino Acid Units in Commercial Monascus Pigments. Chem. Pharm. Bull. 1997, 45, 227–229. [Google Scholar] [CrossRef]
- Srianta, I.; Zubaidah, E.; Estiasih, T.; Iuchi, Y.; Harijono; Yamada, M. Antioxidant Activity of Pigments Derived from Monascus purpureus Fermented Rice, Corn, and Sorghum. Int. Food Res. J. 2017, 24, 1186–1191. [Google Scholar]
- Akihisa, T.; Tokuda, H.; Yasukawa, K.; Ukiya, M.; Kiyota, A.; Sakamoto, N.; Suzuki, T.; Tanabe, N.; Nishino, H. Azaphilones, Furanoisophthalides, and Amino Acids from the Extracts of Monascus pilosus-Fermented Rice (Red-Mold Rice) and Their Chemopreventive Effects. J. Agric. Food Chem. 2005, 53, 562–565. [Google Scholar] [CrossRef] [PubMed]

| S. aureus (in mm) | S. typhimurium (in mm) | MRSA (in mm) | V. cholerae (in mm) | |
|---|---|---|---|---|
| DMSO | 0 | 0 | 0 | 0 |
| CFDP | 5.77 ± 0.18 | 5.62 ± 0.08 | 6.7 ± 0.12 | 6.14 ± 0.9 |
| MSE | 9.33 ± 0.33 | 7.68 ± 0.2 | 6.42 ± 0.15 | 6.9 ± 0.33 |
| MSM | 5.45 ± 0.05 | 4.33 ± 0.18 | 3 ± 0.67 | 2.78 ± 0.05 |
| Antibiotic (50 µg) | 10 | 12 | 12 | 14 |
| S. aureus (in mm) | S. typhimurium (in mm) | MRSA (in mm) | V. cholerae (in mm) | |
|---|---|---|---|---|
| DMSO | 0 | 0 | 0 | 0 |
| 100 µg | 2.33 ± 0.57 | 2 ± 0.00 | 2 ± 0.05 | 3.33 ± 0.66 |
| 200 µg | 2.67 ± 0.35 | 3 ± 0.33 | 3.5 ± 0.33 | 4.67 ± 0.57 |
| 400 µg | 4.33 ± 0.2 | 3.33 ± 0.57 | 5 ± 0.45 | 7.33 |
| Antibiotic (50 µg) | 8 | 10 | 8 | 10 |
| Analyte No. | Tentative Compound Allotted | Chemical Formula | Retention Time | Structure | Mass Recorded (m/z) | Activity | References |
|---|---|---|---|---|---|---|---|
| 1 | Rubropunctin | C22H30O4 | 4.610 | ![]() | 359.67 | - | [29] |
| 2 | PP-V (Penicillium purpurogenum–Violet) | C23H25NO6 | 8.361 | ![]() | 411.66 | - | [30] |
| 3 | Monasfluore B | C23H28O5 | 10.965 | ![]() | 385.20 | Antioxidant, anti-inflammatory activity | [5,27,28] |
| 4 | Red derivative 1 | C26H31NO6 | 18.173 | ![]() | 453.34 | - | [44] |
| 5 | Monaphilone C | C20H32O4 | 22.019 | ![]() | 337.241 | Anti-proliferative | [31] |
| 6 | Rubaropunctamine | C21H23NO4 | 23.922 | ![]() | 354.25 | Antioxidant, anticancer activity | [5,45,46] |
| 7 | Monascin | C21H26O5 | 24.518 | ![]() | 359.18 | Anticancer, antitumor, antidiabetic, antioxidant, anti-inflammatory, anti-obesity activity | [5,33,34,35,36,37,38] |
| 8 | Monaphilone B | C20H28O4 | 25.028 | ![]() | 333.21 | Anti-proliferative activity | [31] |
| 9 | Purpureusone | C23H34O5 | 25.349 | ![]() | 391.21 | Antifungal activity | [22] |
Disclaimer/Publisher’s Note: The statements, opinions and data contained in all publications are solely those of the individual author(s) and contributor(s) and not of MDPI and/or the editor(s). MDPI and/or the editor(s) disclaim responsibility for any injury to people or property resulting from any ideas, methods, instructions or products referred to in the content. |
© 2023 by the authors. Licensee MDPI, Basel, Switzerland. This article is an open access article distributed under the terms and conditions of the Creative Commons Attribution (CC BY) license (https://creativecommons.org/licenses/by/4.0/).
Share and Cite
Kaur, M.; Goel, M.; Mishra, R.C.; Lahane, V.; Yadav, A.K.; Barrow, C.J. Characterization of the Red Biochromes Produced by the Endophytic Fungus Monascus purpureus CPEF02 with Antimicrobial and Antioxidant Activities. Fermentation 2023, 9, 328. https://doi.org/10.3390/fermentation9040328
Kaur M, Goel M, Mishra RC, Lahane V, Yadav AK, Barrow CJ. Characterization of the Red Biochromes Produced by the Endophytic Fungus Monascus purpureus CPEF02 with Antimicrobial and Antioxidant Activities. Fermentation. 2023; 9(4):328. https://doi.org/10.3390/fermentation9040328
Chicago/Turabian StyleKaur, Mehak, Mayurika Goel, Rahul Chandra Mishra, Vaibhavi Lahane, Akhilesh K. Yadav, and Colin J. Barrow. 2023. "Characterization of the Red Biochromes Produced by the Endophytic Fungus Monascus purpureus CPEF02 with Antimicrobial and Antioxidant Activities" Fermentation 9, no. 4: 328. https://doi.org/10.3390/fermentation9040328
APA StyleKaur, M., Goel, M., Mishra, R. C., Lahane, V., Yadav, A. K., & Barrow, C. J. (2023). Characterization of the Red Biochromes Produced by the Endophytic Fungus Monascus purpureus CPEF02 with Antimicrobial and Antioxidant Activities. Fermentation, 9(4), 328. https://doi.org/10.3390/fermentation9040328










